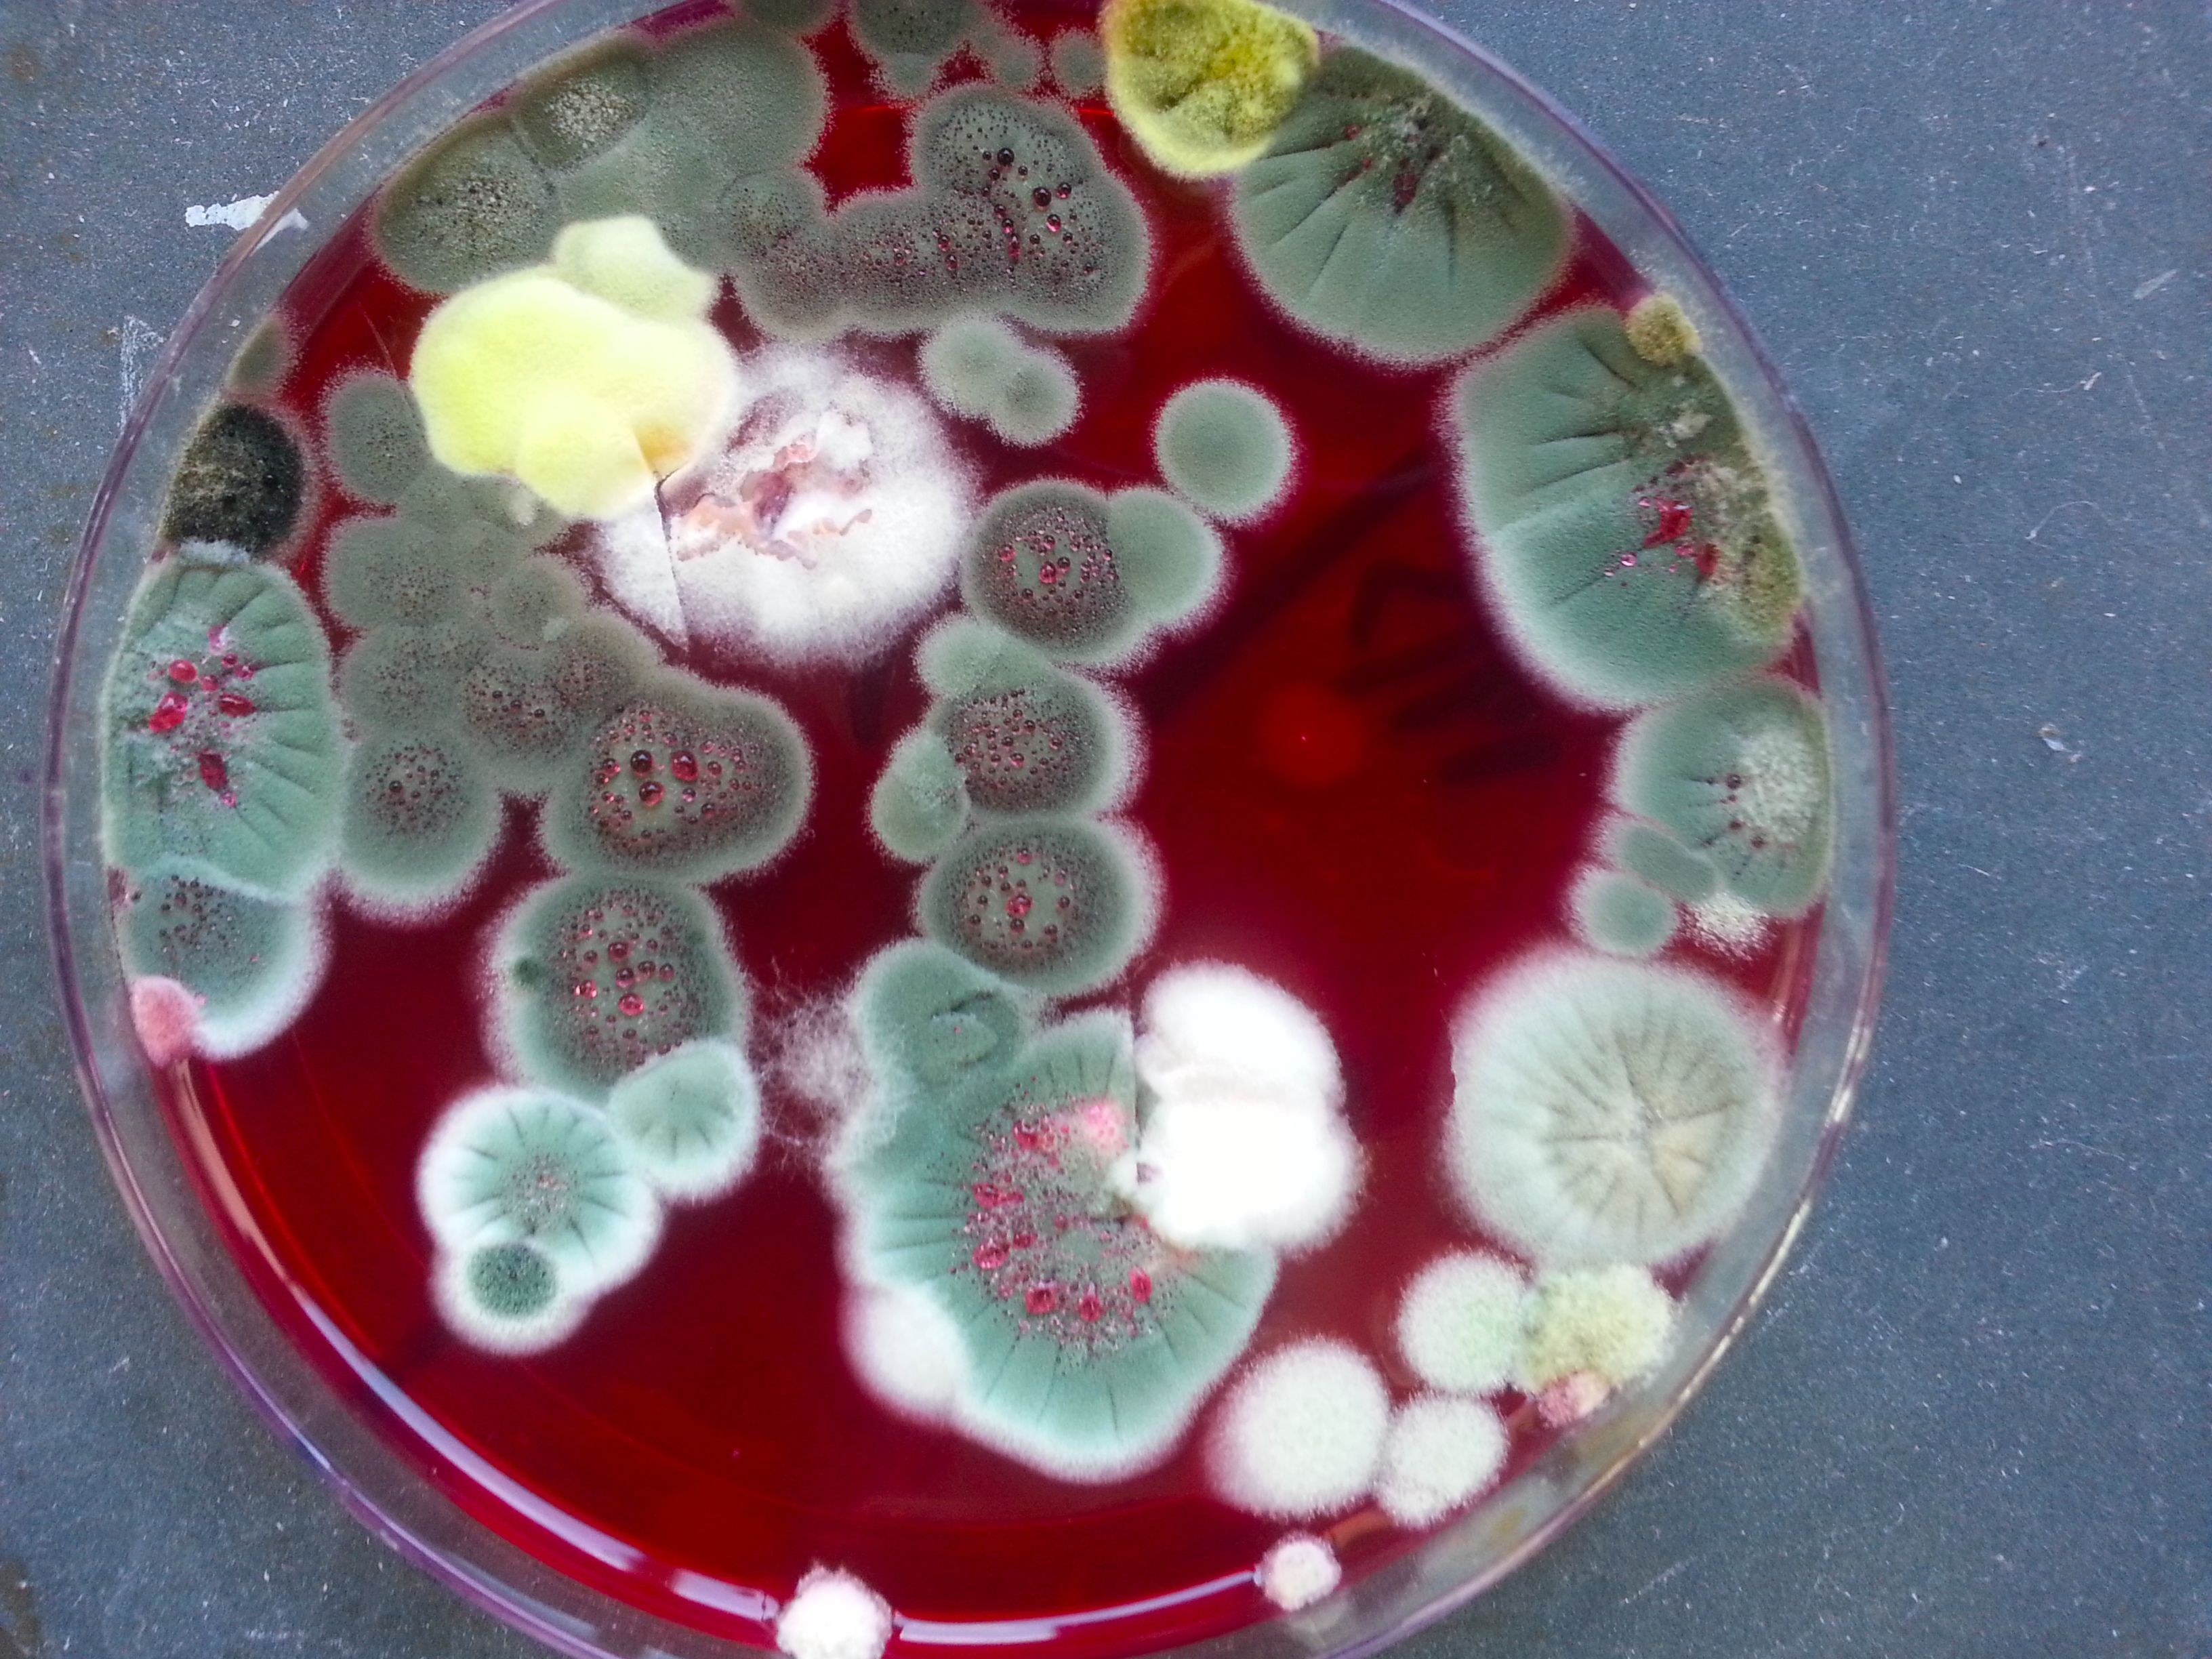

Kia ora, raumati is beginning to warm our patch of earth and the end of the year is drawing near. This special run of online publishing is also coming to an end soon — this is our penultimate issue!
The title of Issue 5 draws together art, craft and everyday life, and is borrowed from artist Guy Ngan, who wrote a piece titled ‘Visual arts and daily bread’ in 1983. I think I first came across it as typewritten sheets in the artist files at Te Papa (while writing for the survey exhibition produced by The Dowse Art Museum and Dunedin Public Art Gallery in 2019), and we’re grateful to Liz Ngan for working with us to republish his essay here. Ngan’s reflection is almost a manifesto — he argues passionately for the fundamental importance of art and artists in society, casting his eye towards what he saw as some of the high points in human history when art and life sat closely together: ancient Greece, the Han and Tang dynasties in China, and Georgian England.
Ngan’s unwavering belief that ‘having art as a part of our everyday living should be as natural and normal as having our daily bread’ is echoed by Steven Park in this issue’s extended essay. Steven will be well known to many of you as an inspiring and thoughtful maker working under the name 6×4. Here, Steven shares his journey and philosophy around craft, its role in nurturing relationships, and what its tendency toward connection might offer us as we navigate the modern world.
The featured artist in this issue is Ruby Chang-Jet White, who exhibited with Steven recently in their show Yawning at the Fray at The Physics Room in Ōtautahi Christchurch. Here we share a snippet of Ruby’s recent practice, including a recipe for you to try. These recent works have seen Ruby explore Chinese postpartum food practices in the wake of becoming a mother herself.
The relationships between food, art and whenua are also at the forefront in the in-depth conversation between Marlar Boon (Mabel’s Burmese Eat & Drink Shop) and Grace and Charles Buenconsejo (Soil of Cultures). Their kōrero traverses food, culture, community, and the dynamics between Aotearoa and their respective homelands, Myanmar and the Philippines.
This issue is another that threads together ideas across time, allowing us to reflect on enduring artistic impulses as well as the ways that ideas evolve and change. We’re thrilled to be republishing a conversation between Kathryn Tsui and Wailin Elliott, two artists connected across generations. It was originally published in cloud ribbon, accompanying Kathryn’s exhibition of the same name in June this year. Wailin passed away in July, and this conversation is an invaluable record of her legacy and her influence on the generations that have followed. Ngā mihi nui, Kathryn, for allowing us to share it again here.
Craft is the art that is all around us! Mā te wā!
✲
About this issue's cover art

The cover art for this issue is a still from a moving-image work by Dilohana Lekamge, commissioned for Like water by water, a 2023 exhibition curated by Simon Palenski and Amy Weng for Blue Oyster and The Physics Room. The work connects two limestone formations: Ram Setu (also known as Adam’s Bridge), a shoal that crosses the Palk Strait between Sri Lanka and India, and scarps and cliffs around Maungati and Kakahu. Through a voiceover, the artist draws together familial, ecological, historical, political and religious narratives — alluding to ‘remote pasts, mythologies, and notions of deep time within the present landscape.’